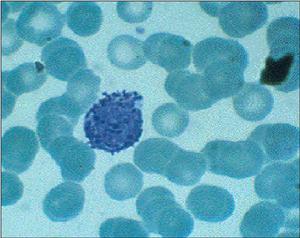
免疫細胞

簡介
 免疫細胞
免疫細胞種類介紹
免疫細胞包括:淋巴細胞(T細胞與B細胞)、單核細胞、中性粒細胞、巨噬細胞(白細胞)。
免疫分子包括:免疫球蛋白、補體、細胞因子、(干擾素、白介素、腫瘤壞死因子)等。
組成
免疫器官
類型:扁桃體、淋巴結、胸腺、脾、骨髓等。
功能:免疫細胞生成、成熟、或集中分布的場所。
免疫細胞
吞噬細胞:①與體液中的殺菌物質構成人體的第二道防線,參與非特異性免疫。
②攝取和處理抗原,參與細胞免疫和體液免疫。
淋巴細胞:①T細胞
②B細胞
免疫活性物質
抗體、淋巴因子及溶解酶等。
T淋巴細胞
 T淋巴免疫細胞
T淋巴免疫細胞T細胞是相當複雜的不均一體、又不斷在體內更新、在同一時間可以存在不同發育階段或功能的亞群,但目前分類原則和命名比較混亂,尚未統一。按免疫應答中的功能不同,可將T細胞分成若干亞群,一致公認的有:輔助性T細胞(TH),具有協助體液免疫和細胞免疫的功能;抑制性T細胞(TS),具有抑制細胞免疫及體液免疫的功能;效應T細胞(TE),具有釋放淋巴因子的功能;細胞毒T細胞(TC),具有殺傷靶細胞的功能;遲發性變態反應T細胞(TD),有參與Ⅳ型變態反應的作用;放大T細胞(TA),可作用於TH和TS,有擴大免疫效果的作用;記憶T細胞(TM),有記憶特異性抗原刺激的作用。T細胞在體記憶體活的時間可數月至數年。其記憶細胞存活的時間則更長。
T細胞是淋巴細胞的主要組分,它具有多種生物學功能,如直接殺傷靶細胞,輔助或抑制B細胞產生抗體,對特異性抗原和促有絲分裂原的應答反應以及產生細胞因子等,是身體中抵禦疾病感染、腫瘤形成的英勇鬥士。T細胞產生的免疫應答是細胞免疫,細胞免疫的效應形式主要有兩種:與靶細胞特異性結合,破壞靶細胞膜,直接殺傷靶細胞;另一種是釋放淋巴因子,最終使免疫效應擴大和增強。
T細胞,是由胸腺內的淋巴幹細胞分化而成,是淋巴細胞中數量最多,功能最複雜的一類細胞。按其功能可分為三個亞群:輔助性T細胞、抑制性T細胞和細胞毒性T細胞。它們的正常功能對人類抵禦疾病非常重要。到目前為止,有關T細胞的演化以及它與癌症的研究取得了不少進展。造血幹細胞又稱多能幹細胞,是存在於造血組織中的一群原始造血細胞。其最大特點是能自身複製和分化,通常處於靜止期,當機體需要時,分裂增殖,一部分分化為定向幹細胞,受到一定激素刺激後,進一步分化為各系統的血細胞系。其中淋巴幹細胞進一步分化有兩條途徑。一些幹細胞遷移到胸腺內,在胸腺激素影響下,大量增殖分化成為成熟淋巴細胞的一個亞群,被稱之為T淋巴細胞。T細胞的“T”字,是採用“胸腺”的拉丁文第一個字母命名的。第二個細胞群在類似法氏囊的器官或組織內受激素作用,成熟並分化為淋巴細胞的另一個亞群,被稱為B淋巴細胞。B細胞的“B”字,是採用“囊”的拉丁文第一個字母命名的。法氏囊是鳥類特有的結構,位於泄殖腔後上方,囊壁充滿淋巴組織。人和哺乳動物無法氏囊,其類似的結構可能是骨髓或腸道中的淋巴組織(集合淋巴結,闌尾等),亦有法氏囊作用。
T細胞不產生抗體,而是直接起作用。所以T細胞的免疫作用叫作“細胞免疫”。B細胞是通過產生抗體起作用。抗體存在於體液里,所以B細胞的免疫作用叫作“體液免疫”。大多數抗原物質在刺激B細胞形成抗體過程中;需T細胞的協助。在某些情況下,T細胞亦有抑制B細胞的作用。如果抑制性T細胞因受感染、輻射、胸腺功能紊亂等因素的影響而功能降低時,B細胞因失去T細胞的控制而功能亢進,就可能產生大量自身抗體,並引起各種自身免疫病。例如系統性紅斑狼瘡,慢性活動性肝炎、類風濕性關節炎等。同樣,在某些情況下,B細胞也可控制或增強T細胞的功能。由此可見,身體中各類免疫反應,不論是細胞免疫還是體液免液,共同構成了一個極為精細、複雜而完善的防衛體系。
B淋巴細胞
B淋巴細胞亦可簡稱B細胞。來源於骨髓的多能幹細胞。在禽類是在法氏囊內發育生成,故又稱囊依賴淋巴細胞(bursa dependent lymphocyte)/骨髓依賴性淋巴細胞簡稱B細胞,是由骨髓中的淋巴幹細胞分化而來。與T淋巴細胞相比,它的體積略大。這種淋巴細胞受抗原刺激後,會增殖分化出大量漿細胞。漿細胞可合成和分泌抗體並在血液中循環。B細胞淋巴瘤是一種最常見的淋巴細胞白血病,有關這種疾病的研究不斷湧現。在哺乳類是在類囊結構的骨髓等組織中發育的。又稱骨髓依賴淋巴細胞。從骨髓來的幹細胞或前B細胞,在遷入法氏囊或類囊器官後,逐步分化為有免疫潛能的B細胞。成熟的B細胞經外周血遷出,進入脾臟、淋巴結,主要分布於脾小結、脾索及淋巴小結、淋巴索及消化道黏膜下的淋巴小結中,受抗原刺激後,分化增殖為漿細胞,合成抗體,發揮體液免疫的功能。B細胞在骨髓和集合淋巴結中的數量較T細胞多,在血液和淋巴結中的數量比T細胞少,在胸導管中則更少,僅少數參加再循環。B細胞的細胞膜上有許多不同的標誌,主要是表面抗原及表面受體。這些表面標誌都是結合在細胞膜上的巨蛋白分子。B1細胞為T細胞非依賴性細胞。B2為T細胞依賴性細胞。B細胞在體記憶體活的時間較短,僅數天至數周,但其記憶細胞在體內可長期存在。
K淋巴細胞
 K淋巴細胞
K淋巴細胞NK淋巴細胞
NK細胞(natural killer cell,自然殺傷細胞)是與T、B細胞並列的第三類群淋巴細胞。NK細胞數量較少,在外周血中約占淋巴細胞總數的15%,在脾內約有3%~4%,也可出現在肺臟、肝臟和腸黏膜,但在胸腺、淋巴結和胸導管中罕見。NK細胞較大,含有胞漿顆粒,故稱大顆粒淋巴細胞。NK細胞可非特異直接殺傷靶細胞,這種天然殺傷活性既不需要預先由抗原致敏,也不需要抗體參與,且無MHC限制。
NK細胞殺傷的靶細胞主要是腫瘤細胞、病毒感染細胞、較大的病原體(如真菌和寄生蟲)、同種異體移植的器官、組織等。
NK細胞表面受體(NKR)可以識別被病毒感染的細胞表面表達的多糖分子。NK細胞的殺傷效應是由其活化後釋放出的毒性分子介導,如穿孔素、顆粒酶和TNFα(腫瘤壞死因子)等。
免疫細胞分離技術
淋巴細胞的分離
 免疫細胞
免疫細胞取肝素抗凝血1m1加Hanks液1m1稀釋後,沿管壁徐徐滴流疊加盛有2m1淋巴細胞分離液的試管內(注意勿與分離液混合,然後2000r/min水平離心20min,管內分為4層,自上而下依次為血漿,單個核細胞,顆粒白細胞、紅細胞(圖2—1)。用毛細管伸至單個核細胞層中(位於細胞分離液與血漿的界面上),沿管壁輕輕吸出全部細胞。然後用Hanks液洗兩次,每次2000r/min離心10min,最後用RPMIl640培養液將細胞配成2×106/m1的細胞懸液備用。
T 細胞及B 細胞的分離
將淋巴細胞懸液通過尼龍棉柱,B細胞粘附於尼龍棉上,T細胞則不粘附,先用RPMIl640培基洗脫尼龍棉柱,流下的細胞懸液含有豐富的T細胞。然後用力反覆擠壓尼龍柱、擠出粘附在尼龍棉上的B細胞,並用少量的RPMIl640培基洗脫,此細胞懸液含有豐富的B細胞。尼龍柱(塑膠管)的長短和尼龍棉的多少,視分離細胞的多少而定。
CD4細胞及CD8細胞的分離
⑴CD4細胞的分離:將一定量的T細胞懸液通過一根SephDdexC—10柱,然後用少量的RPMll640培養洗滌,收穫的細胞懸液約含85%的CD4細胞。⑵CD8細胞分離:用Tris緩衝液稀釋羊抗鼠IgG(濃度為10μg/m1)包被一平皿表面,然後放置4℃過夜,沒有包被上的抗體用PBS洗淨。然後將已標記有抗CD8單克隆抗體的T細胞(細胞濃度為1×l07/m1)3m1加入上述的平皿內,4℃放置2小時,用PBS輕輕洗淨末粘附的細胞,然後用毛細管加入10m1PBS吹打。收集的脫落細胞經洗滌後懸浮在RPMIl640培基中備用。CD4細胞亦可用此法分離。
單核巨噬細胞的分離
單核巨噬細胞有粘附塑膠或玻璃表面的特性,而淋巴細胞則無此特性,藉此可將這兩類細胞分開,其方法簡述如下。將待分離的細胞懸液(如實物動物的腹腔液)加入適當大小的塑膠或玻璃平皿內,置於37℃C02溫箱內溫育1小時,然後用RPMI1640培基輕輕漂洗平皿表面,去除非粘附細胞,再將粘附有細胞的平皿表面用上述培基輕輕洗刷,收集粘附的單核巨噬細胞。如果要獲得純度較高的單核巨噬細胞,可重複上述過程。
最新研究
研究顯示免疫細胞有時促進癌細胞生長
免疫細胞
免疫細胞據英國科學促進會主辦的“阿爾法伽利略”科學新聞網站2008年3月28日報導,美國加利福尼亞大學舊金山分校研究人員戴維·德納多在柏林召開的一個國際會議上,報告了癌細胞是如何利用免疫細胞在體內快速生長和擴散的。
德納多說,受傷感染細菌後,人體能很好地保護自身。免疫細胞能識別病原體,引發炎症以限制感染。傷口癒合時,炎症消退,免疫細胞也撤退。有些免疫細胞遇到癌細胞時也會引發炎症,但與普通創傷不同的是,這些免疫細胞通常不撤退,而是產生一種持久的慢性炎症,“因此被稱之為永不癒合的腫瘤創傷”。
德納多說,在腫瘤創傷癒合過程中,被吸引到傷口處的免疫細胞不僅抗擊入侵者,同時也產生生長因子,允許癌細胞繼續增生擴散。此外,人體內也會有新血管形成,向受傷組織提供氧和營養物。“這種新血管通常能加速傷口癒合,但癌細胞會利用它們來增生”。
德納多說,他們正在研究阻止這類發炎過程的方法。有關研究已經表明,有些類型的腫瘤很少在定期服用阿司匹林的患者身上發生轉移,因為阿司匹林能抑制發炎,因而能阻礙腫瘤擴散。
提高免疫細胞
藉助睡眠
睡眠與人體免疫力密切相關。著名免疫學家通過“自我睡眠”試驗發現,良好的睡眠可使體內的兩種淋巴細胞數量明顯上升。而醫學專家的研究表明,睡眠時人體會產生一種稱為胞壁酸的睡眠因子,此因子促使白血球增多,巨噬細胞活躍,肝臟解毒功能增強,從而將侵入的細菌和病毒消滅。
保持樂觀的態度
 自我免疫
自我免疫可以維持人體於一個最佳的狀態,尤其是在現今社會,人們面臨的壓力很大,巨大的心理壓力會導致對人體免疫系統有抑制作用的荷爾蒙成分增多,所以容易受到感冒或其它疾病的侵襲。
限制飲酒
每天飲低度白酒不要超過100毫升,黃酒不要超過250毫升,啤酒不要超過1瓶,因為酒精對人體的每一部分都會產生消極影響。即使喝葡萄酒可以降低膽固醇,也應該限制每天一杯,過量飲用會給血液與心臟等器官造成很大破壞。
參加運動
專家進行的3項研究指出,每天運動30到45分鐘,每周5天,持續12周后,免疫細胞數目會增加,抵抗力也相對增加。運動只要心跳加速即可,晚餐後散步就很適合。
補充維生素
每天適當補充維生素和礦物質。專家指出,身體抵抗外來侵害的武器,包括干擾素及各類免疫細胞的數量與活力都和維生素與礦物質有關。
改善體內生態環境
用微生態製劑提高免疫力的研究和使用由來已久。研究表明,以腸道雙歧桿菌、乳酸桿菌為代表的有益菌群具有廣譜的免疫原性,能刺激負責人體免疫的淋巴細胞分裂繁殖,同時還能調動非特異性免疫系統,去“吃”掉包括病毒、細菌、衣原體等在內的各種可致病的外來微生物,產生多種抗體,提高人體免疫能力。對於健康人來說,不妨“食療”,多吃些乳酸菌飲料;而健康邊緣人群,可以用微生態製劑來調節體內微生態平衡。能提高免疫力的食品1.靈芝:靈芝可增強人體的免疫力,這是因為靈芝含有抗癌效能的多糖體,此外,還含有豐富的鍺元素。鍺能加速身體的新陳代謝,延緩細胞的衰老,能通過誘導人體產生干擾素而發揮其抗癌作用;2.新鮮蘿蔔:因其含有豐富的干擾素誘導劑而具有免疫作用;3.人參蜂王漿:能提高機體免疫力及內分泌的調節能力,並含具有防癌作用的蜂乳酸;4.蘑菇、猴頭菇、草菇、黑木耳、銀耳、車養、百合等:都有明顯增強免疫力的作用;5.香菇:香菇所含的香菇多糖能增強人體免疫力。
免疫系統
| 系統 | 自適應與天然 | 體液與細胞 | 補體(過敏毒素) | 固有 |
| 抗原與抗體 | 抗原 (超抗原;變應原) | 半抗原 |
| 表位 (線性;構象) | |
| 抗體 (單克隆抗體; 多克隆抗體;自身抗體) | 多克隆B細胞反應 | 同種異型 | 同種型 | 遺傳型 | |
| 免疫複合物 | |
| 免疫細胞/白細胞 | 淋巴系細胞: T細胞 | B細胞 | NK細胞 |
| 髓系細胞:肥大細胞 | 嗜鹼性粒細胞 | 嗜酸性粒細胞 | 巨噬細胞 | |
| 吞噬細胞:中性粒細胞 | 巨噬細胞/網狀內皮系統 | |
| 專職型 APCs:樹突狀細胞 | 巨噬細胞 | B細胞 | |
| 免疫與耐受 | 作用:免疫性 | 自身免疫 | 變態反應 | 炎症 | 交叉反應性 |
| 無作用:耐受 (中樞耐受;外周耐受;克隆無能;克隆缺失) | 免疫缺損 | |
| 免疫遺傳學 | 體細胞超突變 | V(D)J 重組 | 免疫球蛋白類別轉換 | MHC/HLA |
| 免疫物質 | 細胞因子 | 調理素 | 溶細胞素 |
| 其他 | 診斷免疫學 |
免疫系統/ 免疫學
| 免疫系統 | 它是人體抵禦病原菌侵犯最重要的保衛系統。 |
| 系統 | |
| 抗原與抗體 | 抗原 (超抗原, 變應原) | 半抗原 表位 (線性表位, 構象表位) 抗體 (單克隆抗體, 多克隆抗體, 自身抗體) | 多克隆B細胞反應 | 同種異型 | 免疫球蛋白同種異型 | 遺傳型 | 免疫複合物 |
| 免疫細胞/白細胞 | 淋巴系細胞:T細胞 | B細胞 | NK細胞 髓系細胞:肥大細胞 | 嗜鹼性粒細胞 | 嗜酸性粒細胞 | 巨噬細胞 吞噬細胞:中性粒細胞 | 巨噬細胞 | 網狀內皮系統 抗原遞呈細胞:樹突狀細胞 | 巨噬細胞 | B細胞 |
| 免疫 與 耐受 | 作用:免疫性 | 自身免疫 | 變態反應 | 炎症 | 交叉反應性 無作用:耐受 (中樞耐受, 外周耐受, 克隆無能, 克隆缺失) | 免疫缺損 |
| 免疫遺傳學 | 體細胞超突變 | V(D)J 重組 | 免疫球蛋白類別轉換 | MHC/HLA |
| 免疫物質 | 細胞因子 | 調理素 | 溶細胞素 |
| 其他 | 診斷免疫學 |

